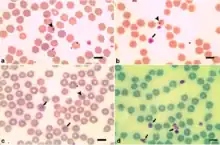

Babesia motasi
| Babesia motasi | |
|---|---|
| |
| Intracellular stages of a Babesia motasi infection | |
| Scientific classification | |
| Domain: | Eukaryota |
| Clade: | Diaphoretickes |
| Clade: | SAR |
| Clade: | Alveolata |
| Phylum: | Apicomplexa |
| Class: | Aconoidasida |
| Order: | Piroplasmida |
| Family: | Babesiidae |
| Genus: | Babesia |
| Species: | B. motasi |
| Binomial name | |
| Babesia motasi Wenyon, 1926 | |
Babesia motasi is a species belonging to Alveolata and the family Babesiidae. In sheep causes babesiosis disease, called "sheep babesiosis". Babesia motasi is quite big protozoa. Length 2,5-5 μm, usually pear-shaped. Is rare in erythrocytes.
Bibliography
- Furmaga, Stanisław (1983). Choroby pasożytnicze zwierząt domowych. Warsaw: Państwowe Wydawnictwo Rolnicze i Leśne. ISBN 83-09-00671-3.
- Cąkała, S. (1981). Choroby owiec. Warsaw: Państwowe Wydawnictwo Rolnicze i Leśne. p. 328. ISBN 83-09-00473-7.